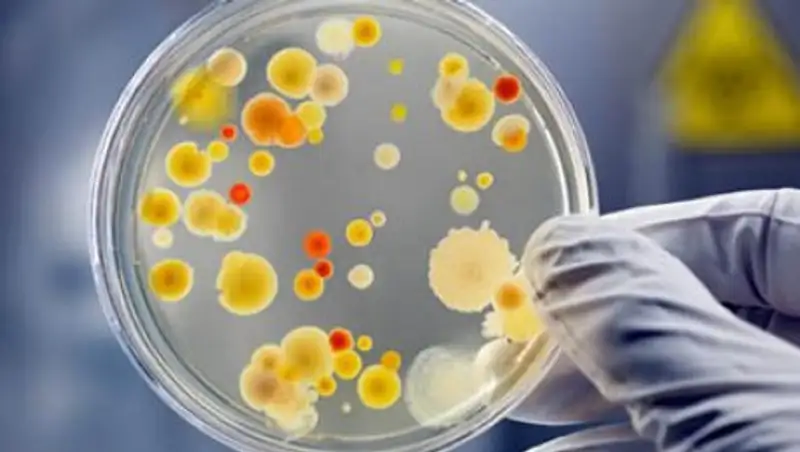

Алматылық ғалымдар обырға қарсы дәрі тапты
Zakon.kz
Zakon.kz
Алматылықтар да қол қуысырып отырған жоқ, оларда 21 ғасыр індетін шөп арқылы емдеуге тырысуда.
Алматы ғалымдары тау қылшасы мен сұр қандыағаштан онкологиялық ауруға қарсы дәрі шығарды. Препараттар шетелдік аналогтарға қарағанда, сапалы әрі арзан. Алайда қалалық дәріханаларға шығару мүмкін болмай отыр, деп хабарлады «Алматы» телеарнасы.
Мамандар қазақстандық дәрімен обырдың тіпті соңғы сатысындағы түрін емдеуге болатынын айтады. Препарат барлық клиникалық сынақтан өтті. Дәріхана сөрелеріне сондай-ақ отандық өнім - тері ауруларына қарсы «Рамон» жақпамайы да шыққан жоқ. Авторлардың айтуынша, бұл Денсаулық сақтау министрлігін қызықтырмай отыр.
«Олар жақсы, арзан қазақтандық дәріге қарағанда, бір батыс препаратын қомақты ақшаға тіркейді. Ал қазақстандық өндірушілерде мұндай ақша жоқ», - деді Әл-Фараби атындағы ҚазҰУ профессоры, химиялық ғылымдар докторы.
Алматыда онкология институтында онкологиялық науқастарды емдейтін 82 препараттың көбі шетелде шығарылатынын мойындады. Арасында барлық әлемнің жалпы кестесі бойынша дайындалған қазақстандық дәрілер де бар. Мысалы, аспирин. Обырға қарсы қазақстандық дәріні шығарумен қарағандылық онкологтар жұмыс істеуде.
Алматылықтар да қол қуысырып отырған жоқ, оларда 21 ғасыр індетін шөп арқылы емдеуге тырысуда.
«Емдеу стандарттары бар. Күллі әлем ғылымы алдында обырға қарсы дәрі табу мәселесі тұр. Өкінішке орай, Нобель сыйлығын әлі ешкім алған жоқ. Әлем күрес жүргізіп жатыр. Дәрі жасау үшін шөп жинаған ғалымдар бізде де бар, қазір олар сынамадан өткізіп көруді ұсынып отыр», - деді ҚазҒЗИ онкология және радилология директоры Диялар Қайдарова.
Әр жыл сайын онкологиялық аурулар арту үстінде. 5 жыл бұрын диагноз 28 мың адамға қойылса, қазір 36 мың. Бұл ретте өлім-жітім 15 пайызға азайды.
Фото: www.russia-on.ru
Поделитесь новостью
Читайте также
Если вы видите данное сообщение, значит возникли проблемы с работой системы комментариев. Возможно у вас отключен JavaScript
















